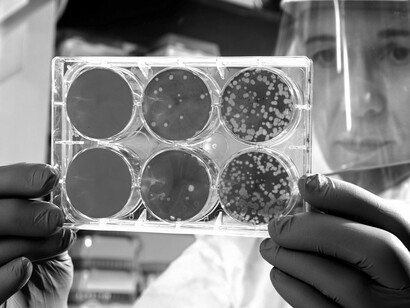
Un científico en el laboratorio con los resultados de un análisis de placa

Si las horas pasaran en vano, el tiempo sería innecesario.
(José Tejada Maury)
Lo que la ciencia moderna ha denominado «superbacteria», en la realidad no existe. Las bacterias resistentes a los antibióticos son un mito de la farmacología moderna.
No existe la superbacteria resistente a los antibióticos, sino son los antibióticos los que son ineficaces, ya que el problema no radica en la molécula química del antibiótico, sino en los acarreadores. Los acarreadores son los portadores del principio activo o los penetradores, es decir, los que ayudan a entrar la molécula que desintegra la cubierta que protege a la bacteria. Las bacterias contienen una cubierta protectora llamada mureína o peptidoglucano. Por lo general, las bacterias están constituidas en un 94% de agua, su única protección es la cubierta o cápsula que la cubre, denominada peptidoglucano o mureína.
Células y bacterias
Existen dos tipos de células, las eucariotas y las procariotas.
Las células procariotas son las unidades básicas de algunos seres vivos, como algunas bacterias. Son simples y no tienen núcleo definido: su material genético (como el ADN) está libre en el citoplasma, es decir, el material que está dentro de la membrana plasmática en la célula. Las bacterias son células procariotas, por lo que, a diferencia de las células eucariotas (de animales, plantas, hongos, etc.), no tienen el núcleo definido ni presentan, en general, orgánulos membranosos internos. Generalmente poseen una pared celular y esta se compone de peptidoglucano.
Se llaman células eucariotas — del griego eu, «verdadero», y karyon,«nuez» o «núcleo» — aquellas que tienen un citoplasma, compartimentado por membranas; destaca la existencia de un núcleo celular organizado, limitado por una envoltura nuclear, en el cual está conteniendo el material hereditario, que incluye al ADN que es la base de la herencia. Se distinguen así de las células procariotas que carecen de núcleo definido, por lo que el material genético se encuentra disperso en su citoplasma. A los organismos formados por células eucariotas se les denomina eucariontes.
El paso de procariotas a eucariotas significó el gran salto en complejidad de la vida y uno de los más importantes de su evolución. Sin este paso, sin la complejidad que adquirieron las células eucariotas no habrían sido posibles ulteriores pasos como la aparición de los organismos pluricelulares; la vida, probablemente, se habría limitado a constituirse en un conglomerado de bacterias. De hecho, a excepción de procariontes (del que proceden), los cuatro reinos restantes (animales, plantas, hongos y protistas) son el resultado de ese salto cualitativo. El éxito de estas células eucariotas posibilitó las posteriores radiaciones adaptativas de la vida que han desembocado en la gran variedad de especies que existe en la actualidad.
Reproducción de las bacterias y resistencia a los antibióticos
¿La alta capacidad de reproducción de las bacterias es clave para justificar la supuesta resistencia a los antibióticos?
Quizá la respuesta se halle en un estudio, dirigido por investigadores del Consejo Superior de Investigaciones Científicas (CSIC) de España y por la Universidad noruega de Ciencias de la Vida, publicado hace cinco años en la revista científica Nature Communications y cuyos revelaciones más importantes se comentan aquí.
Esta investigación ha permitido descubrir cómo es la estructura tridimensional de la proteína PcsB, que es «esencial» en el proceso de división celular del neumococo.
Para Juan A. Hermoso, el codirector del estudio, «el hallazgo es importante porque la clave de la resistencia de las bacterias a los antibióticos estriba en su alta capacidad de reproducción, un mecanismo que desconocíamos hasta ahora».
Una bacteria se divide para dar lugar a dos células hijas cada 20 minutos (en un día da lugar a 4.700 trillones de bacterias). Por tanto, conocer bien los mecanismos de división celular es una parte «crítica» en la lucha contra las infecciones bacterianas.
«Dada la altísima capacidad de reproducción de las bacterias y a sus mecanismos de resistencia a antibióticos, algunos hijos pueden presentar resistencia a los antibióticos, de modo que frente a una infección de 200.000 bacterias, un antibiótico puede eliminar a 199.999», ha señalado Hermoso.
«Pero si queda una bacteria con capacidad de resistencia a ese antibiótico, gracias a su maquinaria de replicación, en pocas horas habrá generado, nuevamente, millones de bacterias resistentes a los antibióticos», ha continuado.
Por eso, de los antibióticos convencionales atacan el proceso de formación la pared bacteriana, una parte esencial para la supervivencia de la bacteria.
Es necesario un cambio de enfoque para comprender el problema
Las bacterias son organismos unicelulares. Existen las células eucariotas y procariotas, hemos dicho. Nos preguntamos: ¿cuál es el mecanismo para que una bacteria se mute tal como lo afirma la microbiología moderna?
Las respuestas evasivas surgen en primer plano. Según la tinción se las clasifica en Gram—positivas o Gram—negativas. Todo profesional tiene el derecho de informarse si una bacteria cualquiera no sólo es Gram—positiva o Gram—negativa, debe saber también si es eucariota, procariota, aeróbica o anaeróbica. Con esto el profesional de la salud se forma un juicio sobre las condiciones del medio en que sobrevive la bacteria y el procedimiento para su destrucción certera sin temor a seguir la muletilla académica de «resistencia a los antibióticos».
Por lo general las bacterias que atacan al organismo humano como los cocos son procariotas; en este sentido podemos afirmar que dada su constitución fisiológica y morfológica es imposible que dicha bacteria sufra una mutación para hacerse resistente a un antibiótico, es un mito académico que nos demuestra lo mal que estamos en materia de filosofía de la ciencia («epistemología»: teoría del conocimiento científico) y que se cumple la contradicción de afirmar que el observar, cuantificar, tabular ya no resuelve el problema porque desconoce la parte intrínseca del mecanismo de funcionamiento no tanto de reproducción sino de la constitución física de las bacterias. Aquí comprendemos que el método científico tradicional es un rotundo fracaso debido a que desconoce los aspectos intrínsecos de algunos mecanismos biológicos o físicos.
Lo que hace que la cubierta protectora de la bacteria se endurezca o se haga impenetrable y el antibiótico no cumpla en apariencia su misión de destruir por lisis a la bacteria, son las condiciones líquidas del medio en que habita, para entendimiento del tema más bien deberíamos llamarlas bacterias trans, para entender que a nivel del metabolismo, los enlaces carbono de la capa mureína o péptidoglicano va sustituyendo átomos de carbono por hidrógeno, sucede como el mecanismo de las grasas, mediante procesos de industrialización, a través de hidrogenación los aceites se van transformando en margarinas y se endurecen.
Pues bien este mecanismo es similar al del cuerpo humano y su proceso digestivo , mientras más aumente la acidez del medio que rodea el hábitat de las bacterias , estos radicales H+ permitirán desplazamientos de átomos de carbono para ser reemplazados por hidrógenos .Esto es lo que endurece la cubierta protectora de la bacteria. Por consiguiente el problema no es que la bacteria sea resistente al antibiótico, sino es el mecanismo de penetración del antibiótico el ineficaz .La cubierta de la bacteria se convierte prácticamente en un ácido graso insaturado.
Por consiguiente si cambiamos la terminología, es decir, que el asunto deje de ser un problema semántico para poder interpretar y llevarlo a la práctica, entender que no debemos llamarla superbacteria, sino bacteria trans, solucionaríamos el problema de una manera sencilla, produciendo los mecanismos de óxido-reducción de las moléculas comprometidas en el proceso de la alta hidrogenación de la cubierta peptidoglucano o mureína , para que las reacciones fisicoquímicas destruyan esta cubierta trans. Muy posiblemente la saturación de grasa por parte de la capa mureína o de peptidoglucano de la bacteria es la que impide la acción del antibiótico sobre el mecanismo de lisis para la destrucción de la bacteria, situación que se ve favorecida por el incremento de la temperatura corporal, un proceso de hidrogenación asociado a las grasas trans, en el cual se saturan las grasas de manera natural debido a la hidrogenación del medio y a la temperatura corporal.
El antibiótico destruye a la bacteria por lisis y no mediante afinidad o paternidad genética selectiva, por consiguiente el argumento de que la bacteria sufre una mutación genética y se hace resistente a los antibióticos carece de fundamento científico.